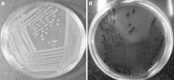

The Determination of Assay for Laccase of Bacillus subtilis WPI with Two Classes of Chemical Compounds as Substrates
- PMID: 24293734
- PMCID: PMC3516662
- DOI: 10.1007/s12088-012-0298-3
The Determination of Assay for Laccase of Bacillus subtilis WPI with Two Classes of Chemical Compounds as Substrates
Abstract
Ligninolytic enzyme complexes are involved in lignin degradation. Among them laccases are outstanding because they use molecular oxygen as a co-substrate instead of hydrogen peroxide as used by peroxidases. Bacterial laccase of Bacillus genus was first reported in Claus and Filip (Microbiol Res 152:209-216, 1997), since then more bacterial laccases have been found. In this research, laccase-producing bacteria were screened from pulp and paper industry wastewater, bagass and sugarcane rhizosphere. Nutrient agar medium containing 0.5 mM of guaiacol was used. It was observed that the laccase-producing strains developed brown colour from which 16 strains of Bacillus were identified. One of the isolated strains was identified as Bacillus subtilis WPI based on the results of biochemical tests and 16S rDNA sequence analysis. This strain showed laccase-like activity towards the oxidizing substrates ABTS and guaiacol. In this study guaiacol was used as the substrate of laccase activity assay. For determination of laccase activity of this isolate guaiacol was used as a substrate of assay for the first time in this study. SDS-PAGE and Native-PAGE confirmed the presence of laccase.
Keywords: Bacillus subtilis; Guaiacol; Isolation; Laccase; Pulp and paper wastewater.
Figures

References
-
- Claus H, Filip Z. The evidence of a laccase-like enzyme activity in a Bacillus sphaericus strain. Microbiol Res. 1997;152:209–216. doi: 10.1016/S0944-5013(97)80014-6. - DOI
-
- Thurston CF. The structure and function of fungal laccases. Microbiology. 1994;140:19–26. doi: 10.1099/13500872-140-1-19. - DOI
-
- Desai SS, Nityanand C. Microbial laccases and their application. Asian J Biotechnol. 2011;3:98–124. doi: 10.3923/ajbkr.2011.98.124. - DOI
-
- Pazarlıoglu NK, Sariisik M, Telefoncu A. Laccase: production by Trametes versicolor and application to denim washing. Process Biochem. 2005;40(1):673–1678.
-
- Xu F. Applications of oxidoreductases: recent progress. Ind Biotechol. 2005;1:38–50. doi: 10.1089/ind.2005.1.38. - DOI
LinkOut - more resources
Full Text Sources